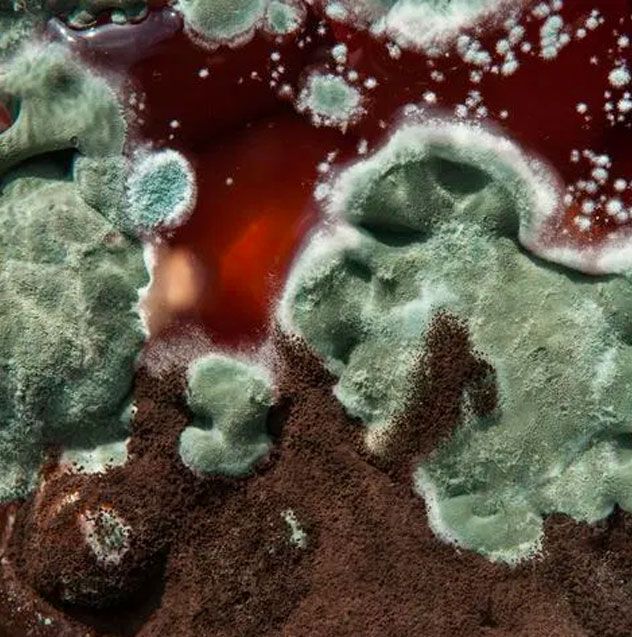

How to find the best mold inspector in Toronto
It is important to find the best mold removing company as it’s a matter of your house and for this you should seek help from a professional who’s experienced. Following are the tips that you can follow to find the best mold inspector. Remember each mold inspector would claim to be the best in the town, however you need to be vigilant in this regard.
- Call and ask for price
Initially, make sure to explain the situation of your house and the state of the problem. The examiner ought to likewise ask you various questions to figure out what is happening to best assist you. There are times when an investigation isn't required, and they can without much of a stretch advise you via telephone. This is how you gauge the inspector, is he taking time to comprehend your concern(s). Inquire whether the inspector is willing to talk about your concern via telephone and answer any inquiries preceding booking the examination. This is additionally a chance to discover how well the individual on the other line speaks with you. Effective communication is imperative as you have to comprehend the issues and possible ramifications. The initial phone call and the talk with inspector would give you a clear understanding of the inspector’s professional attitude.
- Find Qualified and experienced Inspector
Before hiring the inspector make sure the person is qualified and experienced to help you. This is very important as the mold removal industry isn't yet regulated. Therefore, it is essential to pick an inspector that has enough experience. Professional inspectors give you the guarantee that the mold won’t regrow. This can be identified by asking for certifications and experience before hiring the personnel. A true professional would share the certificate immediately while the imposter would hesitate, so be on the lookout for imposters.
- Mold Inspection process
Experienced and trained mold instructors will inquire the problem in detail to your satisfaction. They will have a checklist with them to make sure all the questions are being answered. It is important for your mold inspector to explain everything in detail and share their company protocols. He should inform you the timeline, treatment needed, and cost. You also want to know their experience, timeline, if the treatment is effective or not. The generic procedure includes
- Trainings
Mold inspectors use various equipment’s and tools to diagnose, confirm and treat mold as hygrometer, air quality pumps, moisture meter etc. It is important to know. It is important to know if they are well equipped and trained to use the tools. Because a few advanced tools usage require proper training.
In a nutshell, to hire the best mold inspector it is important to know the certifications, experience, qualifications, tools and equipment’s and trainings. On the flip side you must also not rush, just relax and take your time. You would eventually find the right inspector, you simply need to put in some effort and call a few numbers.